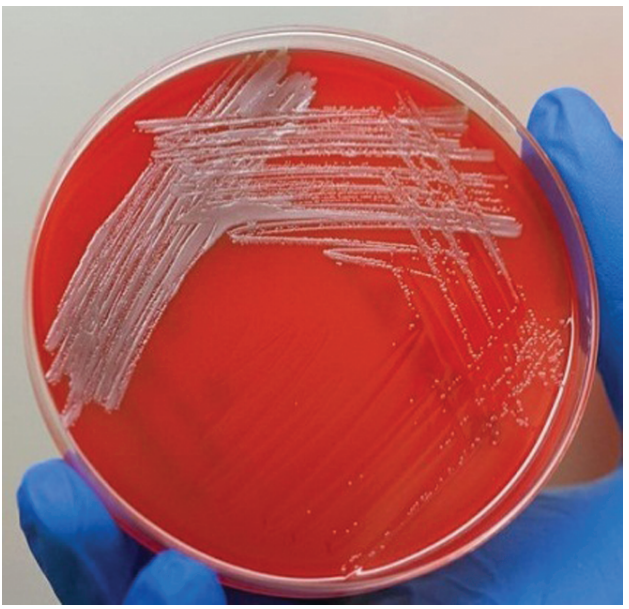
Brucella colonies in blood agar - Brucellacolonies in blood agar

Brucellosis is one of the world’s most widespread zoonoses which is highly infective for humans. Human brucellosis usually presents as an acute febrile illness, but the disease may persist as relapse, chronic localized infection or delayed convalescence. Most cases are caused by Brucella melitensis and all age groups are affected.
Brucellosis, also known as “Undulant fever”, “Mediterranean fever”, or “Malta fever” or “Bang’s disease” is a zoonosis (a disease that can be transmitted to humans from animals) and the infection is almost invariably transmitted to people by direct or indirect contact with infected animals or their products. Humans are the accidental host.
According to WHO, Brucellosis is an important human disease in many parts of the world, especially in the Mediterranean countries of Europe, north and east Africa, the Middle East, Asia, and America.
Main symptom of Brucellosis is recurrent bouts of high temperature. Physicians tend to misdiagnose brucellosis as drug-resistant malaria in tropical countries.

General characteristics ofBrucellaspp
- Causative agent of brucellosis (a zoonotic disease)
- Isolated by British army doctor, David Bruce (1886)
- Small gram-negative coccobacilli without a capsule
- Strictly aerobic, catalase and oxidase positive
- Normal flora of genitourinary tract of wild and domestic animals
- Humans are the accidental host.
- Survive as intracellular organisms
Out of six major species ofBrucella,only 4 are major pathogenic species,
- Brucella melitensis: goats/sheep: Most pathogenic
- Brucella abortus: cattle
- Brucella suis: pigs
- Brucella canis: dogs
Mode of transmission
Humans are generally infected with brucellosis in one of three ways:
- Eating undercooked meat or consuming unpasteurized/raw dairy products
- Bacteria entering the body through skin wounds or mucous membranes
- Breathing in the bacteria that cause brucellosis (Person-to-person transmission is rare)
Portal of entry:
- Contaminated dairy products and animal feed: Digestive tract
- Aerosols: Respiratory tract
- Contacts with infected animals on farms or in slaughterhouses: Skin.
Brucellas multiply and move through the lymphatic system into the blood and results in acute bacteremia within 1 to 6 weeks.
Host defense: macrophages but some survive within these cells (Protection from Ab)
Localize in the endothelial system, namely lymph nodes, liver, spleen, and bone marrow and results in formation of granuloma, with lymphocytes and epithelioid giant cells, which can progress to form focal abscesses and caseation.
Pathogenesis mechanism ofBrucella is not well defined, though it has been found that endotoxin is a major virulence factor. They are no formation of exotoxins.
Laboratory diagnosis
Presumptive diagnosis of brucellosis can be made by demonstrating high or rising antibody titers to Brucella antigens. Diagnosis is confirmed with the isolation of the organism from blood, bone marrow, or tissue cultures.
Evidence in support of the diagnosis of Brucellosis includes:
- A history of recent exposure to a known or probable source of Brucella spp.
- Isolation of Brucella spp. from the patient.
- Demonstration by validated polymerase chain reaction (PCR) of the presence of Brucella genetic material in blood or other tissue samples.
- Demonstration by a validated serological method of Brucella antigen in blood or other tissue samples.
- Demonstration of a rise in antibody titre in any serological test for brucellosis in the absence of exposure to any known source of cross-reacting antigens.
- Demonstration of a high sustained IgG antibody titre in the agglutination, complement fixation or ELISA tests with standardized antigens.
Isolation ofBrucellaspp (Culture method)
Caution: Brucellae are highly infectious (Hazard group 3) pathogens. Laboratory-acquired infections can occur following accidental inoculation or inhalation of the organisms. Blood should be collected with great care and the creation of aerosols should be minimized and if possible procedures producing aerosols must be carried under a safety cabinet.
Sample: Blood (5 ml), Bone marrow, Lymph nodes, liver biopsy
Brucella organisms survive the intracellular killing by phagocytes and polymorphonuclear leukocytes and localize in the reticuloendothelial system
Blood cultures are positive in 53.4 to 90% of patients with brucellosis. A biphasic medium (Castenda method of blood culture) consisting of a solid and a liquid phase in the same blood culture is used for the isolation of the Brucella.
Brucella is a very slow-growing organism so the Blood culture must be incubated for a period of 6-8 weeks before discarding as culture negative. Periodic transfer (subculture) to serum-supplemented solid media every 3-5 days is needed to isolate the organism.
Brucella grows on both blood agar and chocolate agar but not on MacConkey agar. Colonies are pinpoint at 24 hours and are easily visible as white, nonhemolytic colonies at 48 hours.

Serological technique
Rose Bengal Plate testis the most widely used screening test for brucellosis. It can be used as spot agglutination test using stained antigen. In the absence of an acute phase specimen, a titer of at least 1: 160 in the convalescent-phase serum sample is diagnostic. Serological methods include agglutination, complement fixation and ELISA.
Antigen used: Killed suspension of standard strain of Brucella abortus
In Brucellosis, both IgM and IgG antibodies appear in 7-10 days after the onset of clinical infections. As the disease progresses, IgM antibodies decline, while IgG antibodies persist or increase in titre. In chronic Brucellosis, only IgG is present but IgM is absent.
Prevention of brucellosis in humans: Key points
The prevention of human brucellosis is based on occupational hygiene and food hygiene. The best way to prevent brucellosis infection is to be sure you do not consume undercooked meat and unpasteurized dairy products, including milk, cheese and ice cream.
- All dairy products should be prepared from heat-treated milk.
- Consumption of raw milk or products made from raw milk should be avoided.
- Meat should be adequately cooked.
- Special precautions should be taken by laboratory workers.
- Physicians and health workers should be aware of the possibility of brucellosis.
- Public health education should emphasize food hygiene and occupational hygiene.
- Vaccination is not generally recommended.
References
- Corbel M. J. (1997). Brucellosis: an overview. Emerging infectious diseases, 3(2), 213–221. https://doi.org/10.3201/eid0302.970219
- Hayoun MA, Muco E, Shorman M. Brucellosis. [Updated 2023 Apr 29]. In: StatPearls [Internet]. Treasure Island (FL): StatPearls Publishing; 2023 Jan-. Available from: https://www.ncbi.nlm.nih.gov/books/NBK441831/
- Głowacka, P., Żakowska, D., Naylor, K., Niemcewicz, M., & Bielawska-Drózd, A. (2018). Brucella – Virulence Factors, Pathogenesis and Treatment. Polish journal of microbiology, 67(2), 151–161. https://doi.org/10.21307/pjm-2018-029